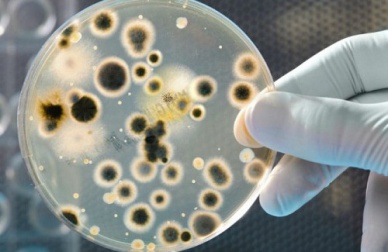
Cosa nascondono le banconote?

Cosa nascondono le banconote?
Durante la giornata vi capita spesso di dover utilizzare i soldi, ma forse non sapete che le banconote nascondono un gran numero di batteri e che, se non curate l’igiene e vi lavate bene le mani, possono compromettere la vostra salute in modo anche pericoloso.
Questa è una buona ragione per lavarsi le mani con una certa frequenza, infatti, grazie a questa semplice abitudine, potremo evitare molti problemi di salute. Quando tocchiamo una banconota, una grande quantità di batteri si trasferisce sulle nostre mani e per poi passare al resto dell’organismo se mettiamo le mani in bocca o ci tocchiamo gli occhi, per esempio.
Grazie ad alcuni studi condotti negli Stati Uniti e in Colombia, si è potuto dimostrare che sulle banconote sono presenti molti batteri responsabili di infezioni, ma anche microrganismi che possono causare diverse patologie che il sistema immunitario non riesce a respingere. È stato dimostrato, inoltre, che sia le banconote sia le monete ospitano circa sette tipi diversi di batteri.
Lo Stafilococco epidermidis (Staphylococcus epidermidis)
Questo genere di batteri può causare infezioni in diverse parti del corpo. Alcuni dei suoi sintomi possono essere: febbre, stanchezza, dolore localizzato, respirazione e battiti accelerati, sudorazione eccessiva, etc.
I Bacilli (Bacillus)
Alcune specie di Bacilli non hanno sintomi, ma altre, invece, risultano patogene sia per gli animali sia per le persone. I diversi ceppi di questo batterio provocano vomito e diarrea dalle cinque alle dieci ore dopo il contagio.
Lo Streptococco (Streptococcus)
Lo Streptococco è responsabile di molte gravi malattie, tra le quali ricordiamo la meningite, la polmonite batterica, la fascite necrotizzante, la faringite e molte altre. Tuttavia, ci sono anche certe specie di questo batterio che non sono patogene.
L’escherichia coli
I sintomi provocati dall’Escherichia coli possono comprendere un forte dolore allo stomaco accompagnato da diarrea che, in molte occasioni, può contenere tracce di sangue. Si può anche manifestare vomito, nausea e febbre lieve. Tutti questi sintomi si manifestano a partire dal terzo e quarto giorno fino al decimo giorno dal contagio.
Ricordate di lavarvi sempre le mani!
Molti di questi batteri si trovano nell’ambiente che ci circonda, per questo è molto facile essere contagiati. Questi microrganismi possono raggiungere il nostro corpo per una semplice negligenza, come ad esempio il non lavarsi le mani prima di mangiare qualcosa. Ricordate che anche se la maggior parte dei batteri a cui siamo esposti può provocare una semplice infezione, esistono batteri che possono provocare una grave gastroenterite e, in casi estremi, portare alla morte.
Visto che è praticamente impossibile evitare di toccare i soldi e di venire, quindi, a contatto con i diversi tipi di batteri che vi risiedono, dobbiamo comunque fare attenzione a lavare molto bene le mani dopo aver toccato i soldi, soprattutto prima di mangiare, prima di toccare qualsiasi parte del nostro corpo o di accarezzare i nostri bambini. Questa semplice abitudine può evitare gravi problemi di salute.
Non dimenticate che…
Le monete possono ospitare fino a 2.400 batteri, alcuni simili a quelli che si trovano sulle banconote. Tuttavia, sulle banconote il numero di batteri aumenta ogni volta che queste passano da una mano all’altra perché i microbi di una persona che è affetta da qualche malattia possono essere trasmessi alla persona che riceve le banconote “contagiate”.
Non dimenticate che le banconote e le monete sono il mezzo più efficace di diffusione e di trasmissione dei batteri alle persone di tutto il mondo, per questo motivo vi raccomandiamo di fare in modo che i bambini non li tocchino. Evitate di toccarvi la bocca, gli occhi e in generale qualsiasi parte del corpo dopo aver toccato i soldi e cercate di mantenere una buona igiene e di lavarvi sempre le mani.
Tutte le fonti citate sono state esaminate a fondo dal nostro team per garantirne la qualità, l'affidabilità, l'attualità e la validità. La bibliografia di questo articolo è stata considerata affidabile e di precisione accademica o scientifica.
- Cecchini, E. (2001). Infectología y enfermedades infecciosas. Madrid: Journal.
- Kumate, J. (1998). Manual de Infectología. Chichuahua: Méndez.
- Wilson, W. R. et al. (2001). Diagnóstico y tratamiento de enfermedades infecciosas. México, DF: Manual Moderno.
- Gedik, H., Voss, T., Voss, A. (2013). Money and transmission of bacteria. Antimicrobial Resistance & Infection Control. 2(1). DOI:10.1186/2047-2994-2-22
- Kuria, J., Wahome, R., Jobalamin, M., Kariuki, s. (2009). Profile Of Bacteria And Fungi On Money Coins. East African medical journal. 86(4):151-5. DOI:10.4314/eamj.v86i4.46943.
- Vriesekoop F., Chen J., Oldaker J., et al. (2016). Dirty Money: A Matter of Bacterial Survival, Adherence, and Toxicity. Microorganisms. 4(4): 42. doi: 10.3390/microorganisms4040042. PMID: 27886085; PMCID: PMC5192525.
- Otto, M. (2009). Staphylococcus epidermidis — the ‘accidental’ pathogen. Nat Rev Microbiol 7, 555–567. https://doi.org/10.1038/nrmicro2182
Questo testo è fornito solo a scopo informativo e non sostituisce la consultazione con un professionista. In caso di dubbi, consulta il tuo specialista.









